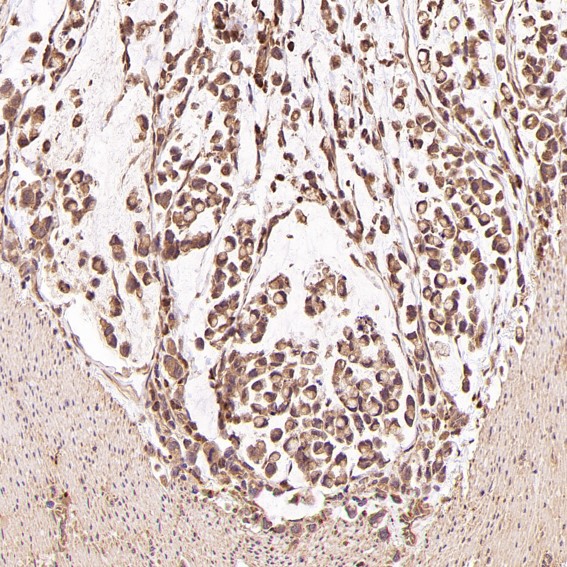

单克隆抗体
CD146 Antibody (CY5209)
UniProt:P43121
Application:WB,IHC,ICC/IF,IP,FC
Reactivity:Human,Mouse,Rat
Source:Rabbit mAb
CD146 Antibody (CY5209)
UniProt:P43121
Application:WB,IHC,ICC/IF,IP,FC
Reactivity:Human,Mouse,Rat
Source:Rabbit mAb
http://www.abways.cn/showproduct.asp?cid=CY5209
ErbB2 (HER2) Antibody (CY5210)
UniProt:P04626
Application:WB,IHC,ICC/IF,IP,FC
Reactivity:Human
Source:Rabbit mAb
ErbB2 (HER2) Antibody (CY5210)
UniProt:P04626
Application:WB,IHC,ICC/IF,IP,FC
Reactivity:Human
Source:Rabbit mAb
http://www.abways.cn/showproduct.asp?cid=CY5210
Phospho-p53 (S392) Antibody (CY5211)
UniProt:P04637
Application:WB,IHC,ICC/IF,IP
Reactivity:Human,Mouse,Rat
Source:Rabbit mAb
Phospho-p53 (S392) Antibody (CY5211)
UniProt:P04637
Application:WB,IHC,ICC/IF,IP
Reactivity:Human,Mouse,Rat
Source:Rabbit mAb
http://www.abways.cn/showproduct.asp?cid=CY5211
Pax2 Antibody (CY5212)
UniProt:Q02962
Application:WB,IHC,FC
Reactivity:Human,Mouse
Source:Rabbit mAb
Pax2 Antibody (CY5212)
UniProt:Q02962
Application:WB,IHC,FC
Reactivity:Human,Mouse
Source:Rabbit mAb
http://www.abways.cn/showproduct.asp?cid=CY5212
Smad5 Antibody (CY5213)
UniProt:Q99717
Application:WB,IHC,ICC/IF,FC
Reactivity:Human,Mouse,Rat
Source:Rabbit mAb
Smad5 Antibody (CY5213)
UniProt:Q99717
Application:WB,IHC,ICC/IF,FC
Reactivity:Human,Mouse,Rat
Source:Rabbit mAb
http://www.abways.cn/showproduct.asp?cid=CY5213

销售咨询
一键电话